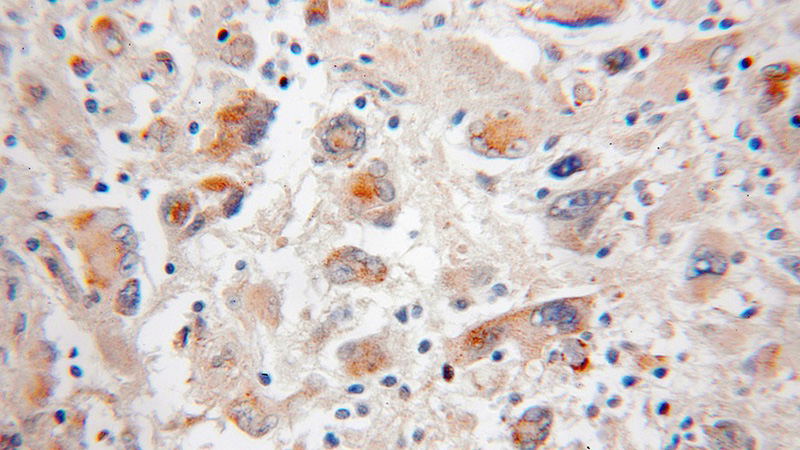
Immunohistochemical of paraffin-embedded human medulloblastoma using Catalog No:113524(SCOT antibody) at dilution of 1:50 (under 10x lens)

-
Product Name
OXCT1 antibody
- Documents
-
Description
OXCT1 Rabbit Polyclonal antibody. Positive IF detected in MCF-7 cells. Positive IHC detected in human medulloblastoma tissue. Positive IP detected in mouse brain tissue. Positive WB detected in human brain tissue, human heart tissue, human kidney tissue, human lung tissue, mouse skeletal muscle tissue, mouse thymus tissue. Observed molecular weight by Western-blot: 56 kDa
-
Tested applications
ELISA, WB, IHC, IF, IP
-
Species reactivity
Human,Mouse,Rat; other species not tested.
-
Alternative names
3 oxoacid CoA transferase 1 antibody; OXCT antibody; OXCT1 antibody; SCOT antibody; SCOT s antibody
-
Isotype
Rabbit IgG
-
Preparation
This antibody was obtained by immunization of OXCT1 recombinant protein (Accession Number: NM_000436). Purification method: Antigen affinity purified.
-
Clonality
Polyclonal
-
Formulation
PBS with 0.1% sodium azide and 50% glycerol pH 7.3.
-
Storage instructions
Store at -20℃. DO NOT ALIQUOT
-
Applications
Recommended Dilution:
WB: 1:1000-1:10000
IP: 1:500-1:5000
IHC: 1:20-1:200
IF: 1:10-1:100
-
Validations

human brain tissue were subjected to SDS PAGE followed by western blot with Catalog No:113524(SCOT antibody) at dilution of 1:400
Immunohistochemical of paraffin-embedded human medulloblastoma using Catalog No:113524(SCOT antibody) at dilution of 1:50 (under 10x lens)

Immunofluorescent analysis of MCF-7 cells, using OXCT1 antibody Catalog No:113524 at 1:25 dilution and Rhodamine-labeled goat anti-rabbit IgG (red).

IP Result of anti-SCOT (IP:Catalog No:113524, 3ug; Detection:Catalog No:113524 1:1000) with mouse brain tissue lysate 4000ug.
-
Background
3-oxoacid-CoA transferase 1 (OXCT1), encoded by nuclear gene, is a mitochondrial CoA transferase required for ketone body degradation. It catalyzes the transfer of CoA from succinyl-CoA to acetoacetate, generating acetoacetyl-CoA. OXCT1 is expressed in brain, heart, and skeletal muscle, but not in liver. This antibody specifically recognizes endogenous OXCT1. (21209089)
-
References
- Cotter DG, d'Avignon DA, Wentz AE, Weber ML, Crawford PA. Obligate role for ketone body oxidation in neonatal metabolic homeostasis. The Journal of biological chemistry. 286(9):6902-10. 2011.
- Maurer GD, Brucker DP, Bähr O. Differential utilization of ketone bodies by neurons and glioma cell lines: a rationale for ketogenic diet as experimental glioma therapy. BMC cancer. 11:315. 2011.
- Cotter DG, Schugar RC, Wentz AE, d'Avignon DA, Crawford PA. Successful adaptation to ketosis by mice with tissue-specific deficiency of ketone body oxidation. American journal of physiology. Endocrinology and metabolism. 304(4):E363-74. 2013.
- Cotter DG, Ercal B, d'Avignon DA, Dietzen DJ, Crawford PA. Impact of peripheral ketolytic deficiency on hepatic ketogenesis and gluconeogenesis during the transition to birth. The Journal of biological chemistry. 288(27):19739-49. 2013.
- Youm YH, Nguyen KY, Grant RW. The ketone metabolite β-hydroxybutyrate blocks NLRP3 inflammasome-mediated inflammatory disease. Nature medicine. 21(3):263-9. 2015.
- Wentz AE, d'Avignon DA, Weber ML. Adaptation of myocardial substrate metabolism to a ketogenic nutrient environment. The Journal of biological chemistry. 285(32):24447-56. 2010.
Related Products / Services
Please note: All products are "FOR RESEARCH USE ONLY AND ARE NOT INTENDED FOR DIAGNOSTIC OR THERAPEUTIC USE"
